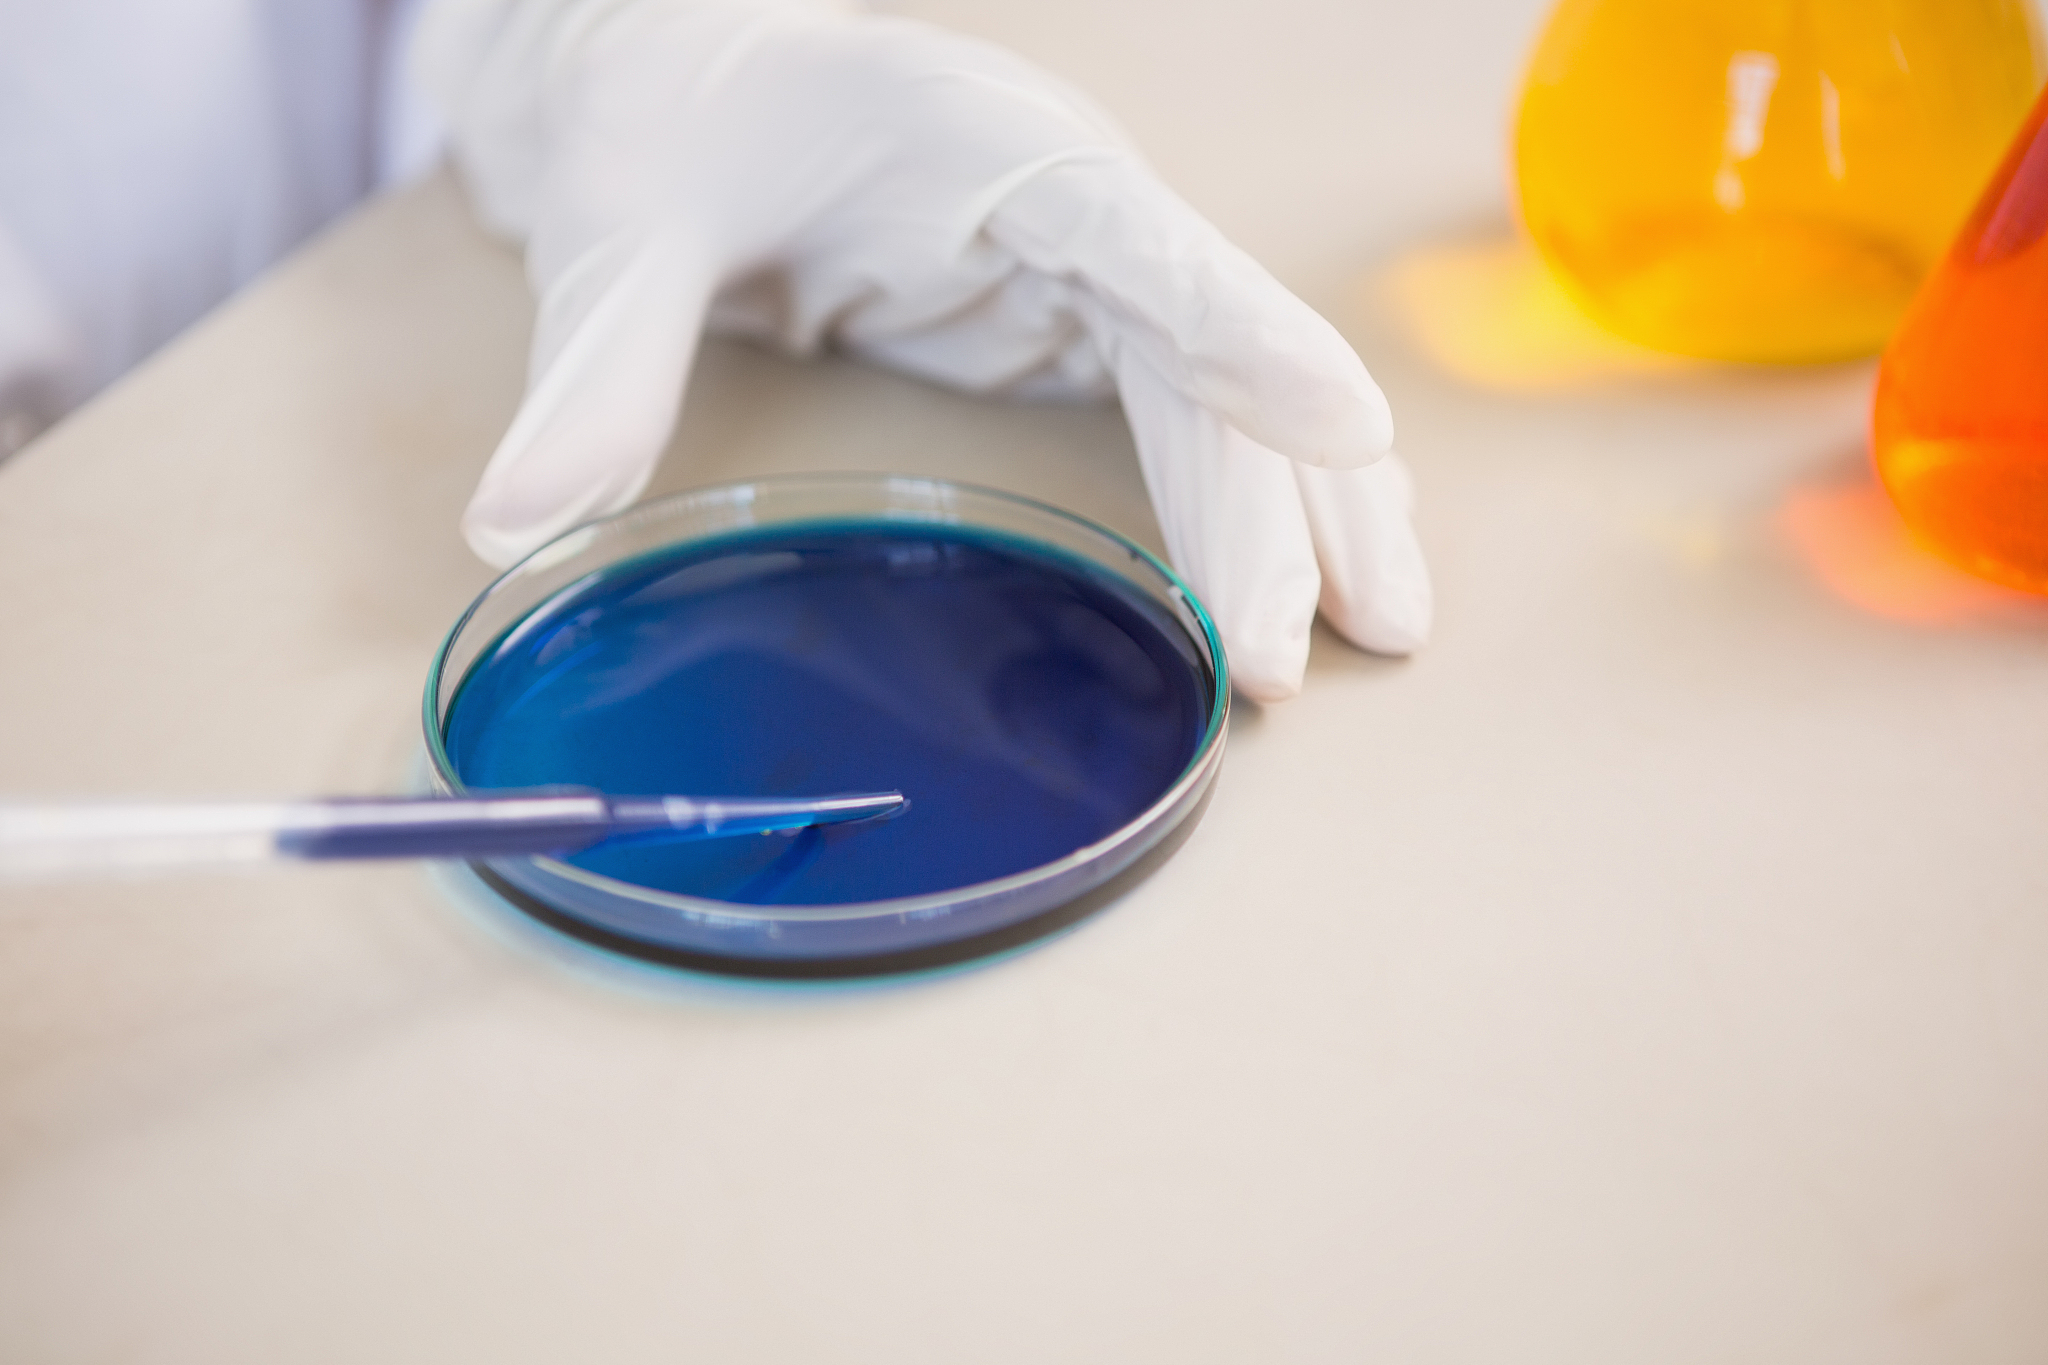
内蒙古科技职业学院工商企业管理专业怎么样

内蒙古科技职业学院工商企业管理专业怎么样
内蒙古科技职业学院工商企业管理专业的教学质量如何?
内蒙古科技职业学院工商企业管理专业是该学院的一门热门专业。这个专业的教学质量如何呢?下面我们来探讨一下。
首先,内蒙古科技职业学院工商企业管理专业的课程设置非常合理,涵盖了各个方面的知识点。学生们可以学到包括管理学、市场营销、财务管理、人力资源管理等在内的多门必修课程,这些课程不仅能够让学生们全面了解企业管理的各个方面,还能够为学生们未来的就业打下坚实的基础。
其次,内蒙古科技职业学院工商企业管理专业的师资力量也非常雄厚。学院拥有一支高水平的师资队伍,其中不乏具有丰富实践经验和教学经验的教授和讲师。这些老师们不仅能够为学生们提供全面的知识点,还能够引导学生们深入思考企业管理的本质和未来发展趋势。
最后,内蒙古科技职业学院工商企业管理专业的实践教学环节也非常丰富。学院注重培养学生们的实践能力,为学生们提供了多种实践机会,包括企业实习、实验课程、模拟经营等,这些实践环节能够让学生们更好地了解企业管理的实际操作,提高他们的实践能力和综合素质。
综上所述,内蒙古科技职业学院工商企业管理专业的教学质量非常不错,无论是从课程设置、师资力量还是实践教学环节来看,都值得学生们的选择和信赖。
####################
内蒙古科技职业学院工商企业管理专业
作为内蒙古科技职业学院的一门热门专业,工商企业管理专业是一门涵盖广泛的学科,其涉及的知识点非常丰富,包括管理学、市场营销、财务管理、人力资源管理等。作为这个专业的主体,学生们需要具备一定的综合素质和实践能力。
从管理学的角度来看,企业管理是一门非常复杂的学科,需要学生们具备全面的知识和技能。在学习过程中,学生们需要了解企业管理的各个方面,包括组织结构、人力资源管理、市场营销等等。只有这样,才能够更好地为企业的发展做出贡献。
从市场营销的角度来看,企业管理需要学生们具备一定的市场营销能力。学生们需要了解市场的需求和趋势,了解市场营销的各个环节,包括产品策划、广告宣传、销售渠道等等。只有这样,才能够更好地为企业的发展打下坚实的基础。
从财务管理的角度来看,企业管理需要学生们具备一定的财务管理能力。学生们需要了解企业的财务状况,包括资金的流入和流出、成本的控制和核算等等。只有这样,才能够更好地为企业的财务管理提供支持。
从人力资源管理的角度来看,企业管理需要学生们具备一定的人力资源管理能力。学生们需要了解员工的需求和管理,包括招聘、培训、绩效考核等等。只有这样,才能够更好地为企业的人力资源管理提供支持。
总之,内蒙古科技职业学院工商企业管理专业是一门非常重要的学科,学生们需要具备全面的知识和技能,才能够更好地为企业的发展做出贡献
原文地址: https://www.cveoy.top/t/topic/drld 著作权归作者所有。请勿转载和采集!